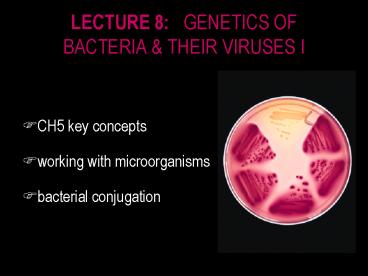

LECTURE 8: GENETICS OF BACTERIA PowerPoint PPT Presentation
1 / 42
Title: LECTURE 8: GENETICS OF BACTERIA
1
LECTURE 8 GENETICS OF BACTERIA THEIR
VIRUSES I
- CH5 key concepts
- working with microorganisms
- bacterial conjugation
2
CHAPTER 5 KEY CONCEPTS
- fertility factor (F) permits bacterial cells to
transfer DNA to other bacteria cells through
conjugation - F can be integrated or cytoplasmic
- when integrated, F can transfer host chromosome
markers through conjugation - bacteriophages can transfer DNA from one
bacterial cell to another in two ways ... - generalized transduction is the transfer of
randomly incorporated bacterial chromosome
fragments - specialized transduction is the transfer of
specific genes near phage integration sites - these methods of gene transfer facilitate
construction of detailed maps of bacterial genomes
3
WORKING WITH MICROORGANISMS
- so far... recombination mapping in eukaryotes
- now... prokaryotes viruses ? resolution
- 3 ways to incorporate recombine DNA in
bacteria - 1. conjugation plasmid-mediated transfer
- 2. transformation absorb from environment
- 3. transduction bacteriophage-mediated transfer
?
4
WORKING WITH MICROORGANISMS
5
WORKING WITH MICROORGANISMS
- binary fission
- known rate C
- liquid medium
- plating ...
- serial dilutions ...
- 1 cell ? 107 cells visible colonies
- or undiluted ...
- lawn
- use both methods
6
WORKING WITH MICROORGANISMS
- strains
- prototrophs wild type
- grow on minimal medium
- auxotrophs mutants
- do not grow on minimal medium
- nutrition
- carbon source
- resistant mutants
7
BACTERIAL CONJUGATION
- do bacteria have genetic exchange recombination
? - Lederberg Tatum, 1946
- Escherichia coli (E. coli)
- single circular chromosome
- haploid
8
BACTERIAL CONJUGATION
- experiment ... contact requirement ?
- 2 strains, gt 1 mutation
- no colonies on A or B ...
- ? no spontaneous back or reversion mutations
- BUT some colonies (10-7) on mixed ...
- ? prototrophs from recombination
9
BACTERIAL CONJUGATION
- experiment ... contact ?
- selective filter prevents cell contact
- no growth (prototrophs) on minimal medium
- ? contact required for recombination
10
BACTERIAL CONJUGATION
- Hayes, 1953
- genetic transfer in bacterial crosses
unidirectional - donor recipient strains ...
- not really sex (? ?) as strains donate unequally
11
BACTERIAL CONJUGATION
- fertility factor F plasmid
- F donor F recipient strains
- F x F ? both F
- unidirectional rolling circle plasmid replication
- F DNA transferred through a pore in the pilus
12
BACTERIAL CONJUGATION
- the F plasmid can integrate into the host
chromosome - generates a high frequency recombinant strain ...
Hfr
13
BACTERIAL CONJUGATION
- Hfr transfers part of the host genome during
conjugation - Hfr x F ? F rarely converted to Hfr or F
- isolate purify Hfr from F for mapping
14
BACTERIAL CONJUGATION
- Hfr x F ? recombination of donor genes in host
15
BACTERIAL CONJUGATION
- Hfr x F ? recombination of donor genes in host
- terms exogenote and endogenote
16
BACTERIAL CONJUGATION
- Wollman Jacob, 1957 gradient of transfer
- selective marker donor is strs recipient is
strr - origin of replication is transferred first
17
BACTERIAL CONJUGATION
- mapping in E. coli by interrupted-mating
- donor genes recombined into host genome
18
BACTERIAL CONJUGATION
- interrupted-mating
- selective markers
- donor is strs
- recipient is strr
- origin of replication transferred first
- 1st transferred markers most frequent in
exconjugants
19
BACTERIAL CONJUGATION
- mapping in E. coli by interrupted-mating
- distance measured in time (min)
20
BACTERIAL CONJUGATION
- bacterial chromosome is circular
- integration of F factor is pseudo-random
- integration in either orientation
21
BACTERIAL CONJUGATION
- bacterial chromosome is circular
- integration of F factor is pseudo-random
- integration in either orientation
22
BACTERIAL CONJUGATION
- F factor integrates by recombination
- pairing regions of homology (hatched)
- episome plasmid with free integrated states
23
BACTERIAL CONJUGATION
- F plasmid episome
- F Hfr replicate
during transfer - Fa x Fa ? Fa
- 103 Fa ? Hfr a
- Hfr a x Fa ?
Fa (exogenote lost)
or Fa (exogenote incorporated)
24
BACTERIAL CONJUGATION
- so far, genetic transfer only
- recombination of Hfr exogenote F endogenote ...
25
BACTERIAL CONJUGATION
- exogenote enters cell ... merozygote partial
diploid - single recombination event (3x, 5x, ...)
nonviable - double recombination event (4x, 6x, ...) viable
26
BACTERIAL CONJUGATION
- exogenote enters cell ... merozygote partial
diploid - single recombination event (3x, 5x, ...)
nonviable - double recombination event (4x, 6x, ...) viable
27
BACTERIAL CONJUGATION
- exogenote enters cell ... merozygote partial
diploid - single recombination event (3x, 5x, ...)
nonviable - double recombination event (4x, 6x, ...) viable
28
BACTERIAL CONJUGATION
- gradient of transfer ? bridge spontaneously
breaks - ? early marker transfer more likely than late
- Hfr leu arg met strs x F leu arg met strr
- ?
29
BACTERIAL CONJUGATION
- determination of gene order by gradient of
transfer - Hfr leu arg met strs x F leu arg met strr
- ?
- of those markers transferred...
Hfr F
leu arg
met
30
BACTERIAL CONJUGATION
- determination of gene order by gradient of
transfer - Hfr leu arg met strs x F leu arg met strr
- ?
- of those markers transferred... which also
recombine?
Hfr F
leu arg
met
31
BACTERIAL CONJUGATION
- determination of gene order by gradient of
transfer - Hfr leu arg met strs x F leu arg met strr
- ?
- met 100
- arg 60
- leu 10
Hfr F
leu arg
met
32
BACTERIAL CONJUGATION
- bias in recovery of markers
- gradient of transfer used for determination of
gene order only - ? to determine map distances, select late marker
to ensure transfer of all relevant genes ... high
resolution mapping
33
BACTERIAL CONJUGATION
- high-resolution mapping by recombinant frequency
34
BACTERIAL CONJUGATION
- high-resolution mapping by recombinant frequency
35
BACTERIAL CONJUGATION
- high-resolution mapping by recombinant frequency
36
BACTERIAL CONJUGATION
- high-resolution mapping by recombinant frequency
37
Schaums Outlines Genetics 3rd Ed., CH12, pp.
321 325 4th Ed., CH10, pp. 349 355
38
Schaums Outlines Genetics 3rd Ed., CH12, pp.
321 325 4th Ed., CH10, pp. 349 355
39
Schaums Outlines Genetics 3rd Ed., CH12, pp.
321 325 4th Ed., CH10, pp. 349 355
40
Schaums Outlines Genetics 3rd Ed., CH12, pp.
321 325 4th Ed., CH10, pp. 349 355
41
BACTERIAL CONJUGATION
- marker transfer by episomes ... F'
- a) integrated F ? Hfr
- b) imprecise excission of F
- c) incorporation of genes
- d) transfer to F
42
BACTERIAL CONJUGATION AND RECOMBINATION MAPPING
PROBLEMS
- in Griffiths chapter 5, beginning on page 179,
try questions 1-3, 5-10, 12, 13, 15, 22, 23,
25-27 - begin with the solved problems on page 177 if you
are having difficulty - look at the way Schaums Outline discusses
conjugation (pp. 338-341) and mapping (pp.
349-355) - try Schaums Outline questions 10.19 and 10.20 on
page 361